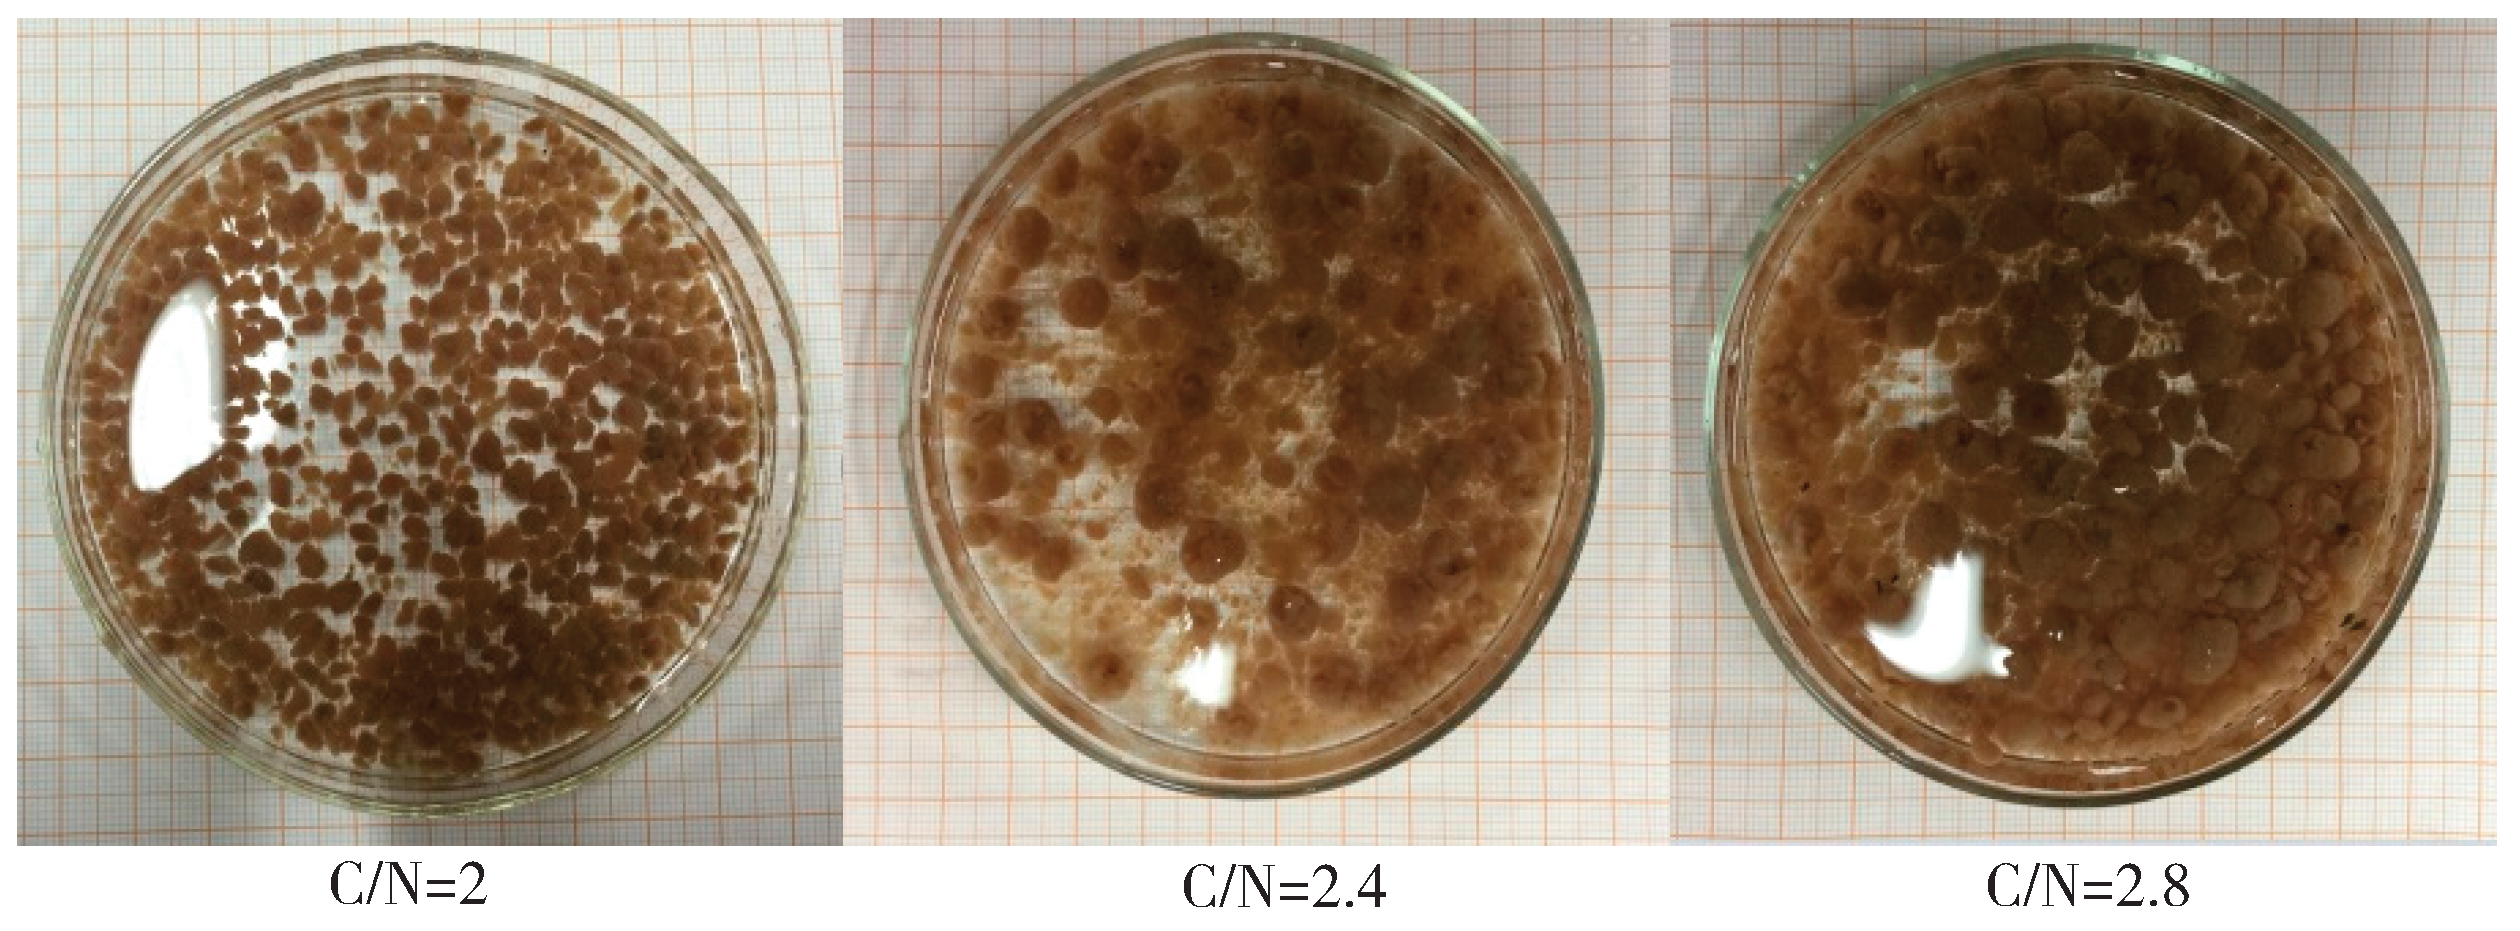

ü厧╗»Ņw┴Ż╬█─Ó╠Ä└ĒĄ═╠╝Ė▀░▒Ą¬ÅU╦«ė░Ēæę“╦ž
ųąć°╬█╦«╠Ä└Ē╣ż│╠ŠW ĢrķgŻ║2018-9-13 8:40:13
╬█╦«╠Ä└Ē╝╝ąg | ģRŠ█╚½Ū“Łh▒Ż┴”┴┐Ż¼ĮĄĄ═Ų¾śIų╬╬█│╔▒Š
ĪĪĪĪé„ĮyĄ─Ž§╗»Ę┤Ž§╗»╔·╬’├ōĄ¬╝╝ąg╠Ä└Ē╠╝į┤│õūŃĪ󥬞ō║╔▌^Ą═Ą─ÅU╦«Ż¼╠Ä└Ē│╔▒ŠĄ═Īóą¦╣¹ŽÓī”ĘĆČ©Ż¼▒╗╬█╦«╠Ä└ĒÅSÅVĘ║▓╔ė├ĪŻ╚╗Č°Ż¼ī”ė┌└¼╗°ØB×Vę║ĪóBų│ÅU╦«Ą╚Ą═C/N▒╚ĪóĖ▀░▒Ą¬ØŌČ╚ÅU╦«Ą─├ōĄ¬╠Ä└ĒŻ¼═∙═∙ę“╠╝į┤▓╗ūŃŻ¼ūįBŽ§╗»Š·Ė╗╝»└¦ļyĄ╚å¢Ņ}ļyęį▀_ĄĮ└ĒŽļĄ─├ōĄ¬ą¦╣¹ĪŻęįü厧╦ß¹}×ķ║╦ą─Ą─Č╠│╠Ž§╗»Ę┤Ž§╗»Īó▓┐ĘųŽ§╗»-ģÆč§░▒č§╗»Ą╚├ōĄ¬╝╝ąg┐╔┐╦Ę■é„ĮyŽ§╗»Ę┤Ž§╗»├ōĄ¬╝╝ągĄ─▓╗ūŃŻ¼Ą½ü厧╗»▀^│╠Ą─┐žųŲ╩ŪČ╠│╠╔·╬’├ōĄ¬▓╗┐╔╗“╚▒Ą─▓┐ĘųŻ¼╩ŪīŹ¼FČ╠│╠├ōĄ¬Ą─ĻPµIĪŻ
ĪĪĪĪģÆč§░▒č§╗»ī”▀M╦«Ąū╬’ę¬Ū¾ć└Ė±Ż¼Č°▒ŖČÓĖ▀░▒Ą¬ÅU╦«ųą╚▒Ę”ü厧╦ß¹}╗∙┘|Ż¼ę“┤╦Ż¼▀@į┌║▄┤¾│╠Č╚╔ŽŽ▐ųŲŲõæ¬ė├Ż¼Š▀ėąü厧╗»ąį─▄Ą─Ņw┴Ż╬█─Óėą═¹ĮŌøQ▀@ę╗ļyŅ}ĪŻ║├č§Ņw┴Ż╬█─ÓŠ▀ėą┴╝║├Ą─│┴ĮĄąį─▄Ż¼ėą└¹ė┌Įž┴¶╬ó╔·╬’Ż¼ęūĖ╗╝»╣”─▄ąį╬ó╔·╬’Ż¼į┘╝ė╔Ž╠žČ©Ą─┐šķgĮYśŗŻ¼╬ó╔·╬’ĘN╚║žSĖ╗Ż¼─═ø_ō¶─▄┴”ÅŖŻ¼š╝Ąž├µĘeąĪŻ¼▀\ąąŠSūo┘Mė├Ą═Ż¼═∙═∙ė├ė┌Ė▀ØŌČ╚ėąÖCÅU╦«ĪóĖ▀║¼¹}Č╚ÅU╦«╝░ČÓĘN╣żśIÅU╦«╠Ä└ĒĪŻ«ö╚╗Ż¼║├č§Ņw┴Ż╠ž╩ŌĄ─┐šķgĮYśŗŻ¼─▄ėąą¦Įž┴¶╔·ķLŠÅ┬²Ą─ūįB╬ó╔·╬’Ż¼ę▓ėą└¹ė┌▓╗═¼╣”─▄├ōĄ¬╬ó╔·╬’Ą─Ė╗╝»Ż¼┐╔īŹ¼F╠žČ©Ą─Ą¬▐D╗»║═ü厧╦ß¹}Ęe└█ĪŻ
ĪĪĪĪ▒ŠčąŠ┐╠Į╦„║├č§Ņw┴Ż╬█─Ó▓┐ĘųŽ§╗»ąį─▄┐ņ╦┘╠ß╔²ĘĮĘ©ęį╝░▀\ąąģóöĄ╚ńžō║╔ĪópHĪó▀M╦«C/NĻPµIąįę“ūėī”▓┐Ęųü厧╗»ąį─▄Ą─ė░Ēæ, ╠Į╦„ęį║├č§Ņw┴Ż╬█─ÓīŹ¼FĘĆČ©ü厧╗»×ķģÆč§░▒č§╗»╠ß╣®└ĒŽļ╗∙┘|Ą─┐╔─▄ąįŻ¼×ķą┬ą═├ōĄ¬╣ż╦ć╠Ä└ĒĄ═C/N▒╚ĪóĖ▀░▒Ą¬ÅU╦«╠ß╣®╝╝ągģóöĄ║═└ĒšōųĖī¦ĪŻ
ĪĪĪĪ1 ▓─┴Ž┼cĘĮĘ©
ĪĪĪĪ1.1 īŹ“×čbų├╝░▀\ąąŚl╝■
ĪĪĪĪ▒ŠīŹ“×╦∙ė├čbų├×ķłAų∙ą╬SBR(sequencing batch reactor)Ż¼ā╚ÅĮ×ķ7 cmŻ¼Ė▀Č╚140 cmŻ¼Ė▀ÅĮ▒╚×ķ20Ż¼▀\ąą▀^│╠ųąīŹļHėąą¦╚▌Ęe×ķ4 LĪŻ▀\ąą▀^│╠ųą┼┼╦«▒╚×ķ50%Ż¼å╬ų▄Ų┌▀M╦«┴┐×ķ2 LĪŻ╚ńłD1╦∙╩ŠŻ¼Ę┤æ¬Ų„Ąū▓┐įOų├ŲžÜŌčbų├Ż¼×ķ╬█─ÓŽĄĮy╠ß╣®╚▄ĮŌč§║═╝¶Ūą┴”Ż¼ė├┴„┴┐ėŗ┐žųŲŲžÜŌ┴┐×ķ2.5 L∙min−1Ż¼▒Ē├µ╔Ž╔²┴„╦┘╝s×ķ1.1 cm∙s−1ĪŻĘ┤欎ĄĮy▀\ąą═©▀^Ģrķg│╠ą“┐žųŲŲ„īŹ¼FĘ┤æ¬▀^│╠Ą─ūįäė┐žųŲŻ¼å╬ų▄Ų┌×ķ3 hŻ¼5 min ▀M╦«Ż¼170 min Ę┤æ¬Ż¼5 min │┴ĮĄĪó┼┼╦«║═ķeų├ĪŻ═©▀^╦«įĪĖū┐žųŲ£žČ╚×ķ(30Ī└2)ĪµŻ¼HRT×ķ6 hĪŻĖ„ļAČ╬▀\ąąĀŅør╚ń▒Ē1╦∙╩ŠĪŻ
ĪĪĪĪłD1 SBR╩ŠęŌłD
▒Ē1 SBRŠ▀¾w▀\ąąĀŅør
ĪĪĪĪ1.2 īŹ“×ė├╦«┼cĮėĘN╬█─Ó
ĪĪĪĪįŁ╦«×ķ╚╦╣ż┼õųŲĄ──ŻöMÅU╦«Ż¼Ųõųąęį┬╚╗»õ@×ķĄ¬į┤(100~500 mg∙L−1Ż¼ęįNėŗ)Īóęę╦ßŌc×ķ╠╝į┤(200~1 400 mg∙L−1Ż¼ęįCODėŗ)Ż¼╩╣ė├╠╝╦ßÜõŌcš{┐ž▀M╦«pH×ķ7.0~8.0ĪŻĮėĘN╬█─ÓüĒūįė┌īŹ“×╩ę┼ÓBŠ▀ėąü厧╗»ąį─▄Ą─║├č§Ņw┴Ż╬█─ÓŻ¼▀M╦«C/N×ķ1Ż¼▀M╦«░▒Ą¬ØŌČ╚300 mg∙L−1Ż¼╚▌Ęežō║╔×ķ1.02 kg∙(m3∙d)−1Ą─Śl╝■Ž┬▀\ąąŻ¼│÷╦«COD║═NH4+-N╚ź│²┬╩Š∙į┌90%ū¾ėęĪŻŅw┴Ż╬█─ÓŲĮŠ∙┴ŻÅĮ×ķ2~2.5 mmĪŻĮėĘNĢrŻ¼╬█─ÓĘ┼ų├1éĆČÓį┬Ż¼Ņw┴Ż╬█─ÓŲĮŠ∙┴ŻÅĮ×ķ2~2.5 mmŻ¼▒Ē├µ│╩║┌╗ę╔½ĪŻį┌SBRųąĮėĘN│┴ĮĄ║¾ØŌ┐sĄ─║├č§Ņw┴Ż╬█─Ó700 mLū¾ėęŻ¼╝ė╦«ų┴ėąą¦╚▌Ęe×ķ4 L║¾Ż¼Ę┤æ¬Ų„ā╚╬█─ÓØŌČ╚×ķ5.09 g∙L−1ĪŻ
ĪĪĪĪ1.3 Ęų╬÷ĘĮĘ©
ĪĪĪĪ▒ŠčąŠ┐╦∙ė├ų„ę¬ųĖś╦Ī¬Ī¬╗»īWąĶč§┴┐(COD)▓╔ė├┐ņ╦┘Ž¹ĮŌĘų╣Ō╣ŌČ╚Ę©; NH4+-N▓╔ė├╝{╩Žįćä®Ęų╣Ō╣ŌČ╚Ę©;NO2−-N▓╔ė├N-(1-▌┴╗∙)-ęęČ■░ĘĘų╣Ō╣ŌČ╚Ę©;NO3−-N▓╔ė├ūŽ═ŌĘų╣Ō╣ŌČ╚Ę©;MLSS▓╔ė├ś╦£╩ųž┴┐Ę©;pH▓╔ė├┘ÉČÓ└¹╦╣╦ßČ╚ėŗ£yČ©ĪŻė╬ļx░▒(free ammoniaŻ¼FA)ėŗ╦Ń╚ń╩Į(1)╦∙╩ŠĪŻ
ĪĪĪĪC FA =C [NH 4 + −N] Ī┴10 −pH e 6 433/(T+273) +10 −pH CFA=C[NH4+-N]Ī┴10-pHe6 433/(T+273)+10−pH(1)
ĪĪĪĪ╩ĮųąŻ║C FA CFA ×ķė╬ļx░▒FAØŌČ╚Ż¼mg∙L−1;T×ķ£žČ╚Ż¼Īµ;C [NH 4 + −N] C[NH4+-N] ×ķ░▒Ą¬ØŌČ╚Ż¼mg∙L−1ĪŻ
ĪĪĪĪ2 ĮY╣¹┼cėæšō
ĪĪĪĪ2.1 ▀M╦«žō║╔ī”║├č§Ņw┴Ż╬█─ÓŽ§╗»ąį─▄Ą─ė░Ēæ
ĪĪĪĪ┐žųŲ▀M╦«C/N=2Ż¼pH×ķ8.0ū¾ėęŻ¼░▒Ą¬ØŌČ╚×ķ100~500 mg∙L−1Ż¼CODØŌČ╚ŽÓæ¬×ķ200~1 000 mg∙L−1ĪŻåóäė▀\ąąų┴42 d ū¾ėęŻ¼ų▓Į╠ß╔²žō║╔▀^│╠ųą╬█─ÓėąÖC╬’╚ź│²║═Ą¬▐D╗»ąį─▄ūā╗»Ż¼ĮY╣¹╚ńłD2╦∙╩ŠĪŻ
ĪĪĪĪłD2 ╠ß╔²▀M╦«žō║╔▀^│╠ųą╦«┘|ģóöĄ║═╬█─ÓØŌČ╚Ą─ūā╗»
ĪĪĪĪĄ┌1~32╠ņ, ▀M╦«░▒Ą¬ØŌČ╚║═žō║╔ĘųäeÅ─100 mg∙L−1║═0.4 kg∙(m3∙d)−1ų╝ē╠ß╔²ų┴300 mg∙L−1║═1.2 kg∙(m3∙d)−1▀^│╠ųąŻ¼Ę┤æ¬Ų„░▒Ą¬╚ź│²┬╩į┌90%ęį╔ŽŻ¼COD╚ź│²┬╩į┌80%ęį╔ŽĪŻī”ė┌ąį─▄┴╝║├Ą─║├č§Ņw┴Ż╬█─ÓŻ¼▀M╦«ėąÖC╬’║═░▒Ą¬ØŌČ╚┐ņ╦┘╠ß╔²Ż¼│÷╦«ü厧╦ß¹}ØŌČ╚ų▓Į╠ßĖ▀Ż¼ü厧╦ß¹}Ęe└█┬╩▀_ĄĮ85%ęį╔ŽŻ¼▀@┼cWUĄ╚[11]蹊┐║├č§Ņw┴Ż╬█─Ó╠Ä└ĒC/N×ķ2Ą─ÅU╦«ĮY╣¹ŽÓ╦ŲĪŻ▀@ę╗īŹ“×ĮY╣¹▒Ē├„Ż¼ü厧╗»Ņw┴Ż╬█─ÓĘ┼ų├1éĆį┬║¾ųžą┬åóäėŻ¼ąį─▄┐ņ╦┘╗ųÅ═Ż¼▓óø]ėą│÷¼F’@ų°Ą─£■║¾Ų┌ĪŻ
ĪĪĪĪŽ§╗»▀^│╠╩▄░▒č§╗»Š·(AOB)║═ü厧╦ß¹}č§╗»Š·(NOB)2ŅÉŽ§╗»Š·Ą─┐žųŲŻ¼ų„ę¬└¹ė├AOB║═NOB╔·└ĒÖCųŲ║═äė┴”īW╠žš„╔ŽĄ─▓Ņ«ÉŻ¼ęųųŲNOBŻ¼╩╣AOB│╔×ķā×ä▌Š·╚║Ż¼īóĘ┤æ¬┐žųŲį┌ü厧╗»ļAČ╬ĪŻ£žČ╚ĪópHĪóDOĪóēAČ╚Ī󥬞ō║╔Ą╚ųTČÓŁhŠ│ę“╦žŻ¼Č╝┐╔ī”AOB║═NOB«a╔·▓╗═¼ė░ĒæĪŻŽÓī”ė┌NOBŻ¼AOBį┌▌^Ą═Ą─DOŁhŠ│Śl╝■Ž┬Ż¼Š▀ėąĖ³ÅŖĄ─č§ėH║═┴”Ż¼ėą└¹ė┌īŹ¼Fü厧╗»ĪŻ▒ŠčąŠ┐ųą┐žųŲŲžÜŌ┴┐×ķ2.5 L∙min−1Ż¼DOūŅĄ═ųĄį┌2.0 mg∙L−1ęį╔ŽŻ¼Ą½ė╔ė┌║├č§Ņw┴Ż╬█─Ó═¼▓Į╚ź│²ėąÖC╬’║═░▒Ą¬Ż¼Ņw┴Ż╬█─Ó▒Ē├µĖ╗║¼┤¾┴┐ė╔«ÉB╬ó╔·╬’«a╔·Ą─EPSŻ¼╝ė╔ŽŅw┴Ż╬█─Ó╠žČ©Ą─┐šķgĮYśŗŻ¼į┌Ņw┴Ż┐v╔ŅĘĮŽ“觥─é„┘|╩▄Ž▐Ż¼╩╣ü厧╦ß¹}č§╗»Š·NOB╩▄ĄĮęųųŲŻ¼«a╔·ü厧╦ß¹}Ęe└█ĪŻīŹ“×ĮY╣¹▒Ē├„Ż¼š¹éĆ▀^│╠ųą│÷╦«Ž§╦ß¹}ØŌČ╚śOĄ═Ż¼ü厧╦ß¹}└█Ęe┬╩Š∙į┌90%ęį╔ŽŻ¼▒Ē¼F│÷┴╝║├Ą─ü厧╗»ąį─▄ĪŻ▀@ų„ę¬╩Ūė╔ė┌Ņw┴Ż╬█─Óį┌░▒Ą¬║═ėąÖC╬’ØŌČ╚┐ņ╦┘╠ß╔²ŪķørŽ┬Ż¼«ÉBŠ·į÷ų│ī¦ų┬EPS╔²Ė▀Ż¼DOį┌Ņw┴Ż╬█─Óųąé„┘|╠▌Č╚×ķü厧╦ß¹}Ęe└█äōįņėą└¹Śl╝■ĪŻō■ł¾Ą└Ż¼░▒Ą¬ØŌČ╚╠ßĖ▀ī”ü厧╦ß¹}č§╗»Š·įņ│╔Ą─ęųųŲū„ė├┤¾ė┌Ųõī”░▒č§╗»Š·Ą─ė░ĒæŻ¼═¼Ģr«ÉBŠ·Ą─į÷ų│▀Mę╗▓ĮŽ„╚§┴╦ü厧╦ß¹}č§╗»Š·ĮY║Ž╚▄觥──▄┴”ĪŻ
ĪĪĪĪŽĄĮy½@Ą├ĘĆČ©ü厧╗»ąį─▄║¾Ż¼į┌Ą┌33╠ņŻ¼▀M╦«░▒Ą¬ØŌČ╚║═žō║╔ĘųäeÅ─300 mg∙L−1║═1.2 kg∙(m3∙d)−1╠ßĖ▀ų┴500 mg∙L−1║═2.0 kg∙(m3∙d)−1Ż¼░▒Ą¬╚ź│²┬╩’@ų°Ž┬ĮĄŻ¼āH×ķ50%ū¾ėęŻ¼│÷╦«░▒Ą¬╩ŻėÓØŌČ╚▀_ĄĮ275 mg∙L−1Ż¼ü厧╦ß¹}│÷╦«ØŌČ╚Ž┬ĮĄų┴130 mg∙L−1ĪŻ▒M╣▄FA/FNAĄ─▀xō±ąįęųųŲ╩ŪīŹ¼Fü厧╗»ŠĆ┬ĘĄ─ųžę¬š{┐žĘĮ╩ĮŻ¼▀M╦«ųą░▒Ą¬ØŌČ╚Ą─╠ß╔²Ż¼FAØŌČ╚┐╔ėąą¦ęųųŲNOBŻ¼ėą└¹ė┌ü厧╦ß¹}└█ĘeŻ¼Ą½▒ŠčąŠ┐į┌░▒Ą¬ØŌČ╚╠ßĖ▀ų┴500 mg∙L−1ĢrŻ¼ü厧╦ß¹}└█Ęe┬╩Ž┬ĮĄŻ¼ų„ę¬╩▄ĄĮ«ÉB╬ó╔·╬’Ą─ė░ĒæĪŻ┤╦Ģr▀M╦«CODØŌČ╚Ė▀▀_1 000 mg∙L−1Ż¼ĮĄĮŌėąÖC╬’Ą─«ÉB╬ó╔·╬’┤¾┴┐Ę▒ų│Ż¼▓ó┼cAOBĖéĀÄDOŻ¼ī¦ų┬AOBĄ─╗Ņąį╩▄ęųųŲĪŻ┤╦═ŌŻ¼░▒Ą¬žō║╔Ą─┐ņ╦┘╔²Ė▀ę▓Ģ■ę╗Č©│╠Č╚╔Žī”░▒č§╗»Š·«a╔·ø_ō¶ąįė░ĒæĪŻ═¼ĢrŻ¼čąŠ┐░l¼FŻ¼┤╦ļAČ╬ŽĄĮy│÷¼FĮ³20%Ą─TNōp╩¦Ż¼šf├„į┌SBR▀\ąąų▄Ų┌ųąŻ¼┤µį┌╚▒解hŠ│Ż¼ėąÖC╬’▒╗ė├ū„ļŖūė╣®¾w▀MąąĘ┤Ž§╗»Ż¼▀Mę╗▓ĮūCīŹį┌▒ŠčąŠ┐ŽĄĮyųąŲžÜŌ┴┐▓╗ūāŻ¼ėąÖC╬’║═░▒Ą¬žō║╔╠ß╔²Ż¼DO│╔×ķAOB╩▄ųŲ╝sĄ─ųžę¬ę“╦žĪŻ
ĪĪĪĪį┌š¹éĆžō║╔▓╗öÓ╠ß╔²▀^│╠ųąŻ¼ŽÓī”ūįB╬ó╔·╬’Ż¼«ÉB╬ó╔·╬’į┌╗∙┘|│õūŃŚl╝■Ž┬Ż¼CODĄ─╚ź│²┬╩ŽÓī”ĘĆČ©(ęŖłD2(a))ĪŻłD2(d)▒Ē├„Ż¼į┌▀M╦«ėąÖC╬’║═░▒Ą¬žō║╔▓╗öÓ╠ß╔²▀^│╠ųąŻ¼╬█─ÓØŌČ╚║═╗Ņąį▓╗öÓ╠ßĖ▀Ż¼MLVSS/MLSSĖ▀▀_0.67Ż¼▓óŪęų„ę¬ęįŅw┴Ż╬█─Óą╬æB┤µį┌ĪŻ×ķ┴╦▒ŻūCŽĄĮyĘĆČ©▀\ąąŻ¼ąĶ▀MąąČ©Ų┌┼┼─ÓĪŻ
ĪĪĪĪ2.2 ▀M╦«pHī”║├č§Ņw┴Ż╬█─Ó▓┐Ęųü厧╗»Ą─ė░Ēæ
ĪĪĪĪĖ„ŅÉ╬ó╔·╬’Č╝ėąŲõ▀m║Žūį╔Ē╔·ķLĄ─ūŅ╝čpHŻ¼pHī”╬ó╔·╬’┤·ųx▀^│╠║═«a╬’┤µį┌ą╬æBę▓Ģ■«a╔·ųžę¬ė░ĒæĪŻį┌ü厧╗»┐žųŲ▀^│╠ųąŻ¼═©▀^┐žųŲ▓╗═¼pHš{╣ØFA╗“FNAŻ¼ėąą¦ęųųŲNOBŻ¼┤┘▀MAOB│╔×ķā×ä▌ĘN╚║ĪŻ▒ŠčąŠ┐╠Įėæ┴╦pHĘųäe×ķ8.0Īó7.5║═7.0Śl╝■Ž┬Ą¬▐D╗»Ą─ė░ĒæŻ¼ęŖłD3ĪŻ
ĪĪĪĪłD3 ▀M╦«pHī”Ą¬ą╬æB▐D╗»Ą─ė░Ēæ
ĪĪĪĪė╔łD3┐╔ęį┐┤│÷Ż¼▀M╦«pHÅ─8.0Ž┬ĮĄų┴7.0Ż¼░▒Ą¬╚ź│²┬╩ųØu╠ß╔²Ż¼│÷╦«░▒Ą¬┤¾Ę∙Ž┬ĮĄŻ¼╔·│╔ü厧╦ß¹}ØŌČ╚▓╗öÓ╠ßĖ▀Ż¼│÷╦«NO2−-N/NH4+-N▒╚ųĄÅ─0.5╠ßĖ▀ĄĮ0.95ū¾ėęĪŻ▀M╦«pHūā╗»ī¦ų┬ė╬ļx░▒(FA)ØŌČ╚░l╔·ūā╗»Ż¼ī”Ą¬ą╬æB▐D╗»«a╔·ų┴ĻPųžę¬Ą─ū„ė├ĪŻ╚ńłD3(b)╦∙╩ŠŻ¼▀M╦«pH×ķ8.0ĢrŻ¼▀M╦«FAØŌČ╚Ė▀▀_48.5 mg∙L−1Ż¼ŽĄĮy░▒Ą¬╚ź│²┬╩āH×ķ46.05%Ż¼«öĖ─ūā▀M╦«pHų┴7.5║¾Ż¼▀M╦«FAØŌČ╚ĮĄĄ═ų┴16 mg∙L−1Ż¼░▒Ą¬╚ź│²┬╩┐ņ╦┘╠ß╔²Ż¼Ą┌51╠ņŻ¼╔²Ė▀ų┴65.12%ū¾ėęĪŻpHų┴7.0ū¾ėęŻ¼▀M╦«FAØŌČ╚×ķ5.1 mg∙L−1Ż¼░▒Ą¬╚ź│²┬╩ĘĆČ©į┌70%ū¾ėęĪŻš¹éĆ▀^│╠ųąŻ¼│÷╦«Ž§╦ß¹}ØŌČ╚Č╝▌^Ą═Ż¼šf├„ŽĄĮyŠS│ųį┌ĘĆČ©Ą─ü厧╗»ļAČ╬ĪŻ▀M╦«ųąĖ▀FAØŌČ╚Ģ■ī”║├č§Ņw┴Ż╬█─Óųą░▒č§╗»Š·įņ│╔▌^ÅŖĄ─ęųųŲ║═ø_ō¶ū„ė├ĪŻ╝Š├±Ą╚╠ß│÷FAø_ō¶ØŌČ╚Ė▀ė┌8.1 mg∙L−1ĢrŻ¼Ė▀žō║╔FAø_ō¶Ģ■ī¦ų┬░▒č§╗»Š·žSČ╚ĮĄĄ═Ż¼FAØŌČ╚į┌10~20 mg∙L−1ĢrĢ■ī”╬ó╔·╬’Ž§╗»▀^│╠įņ│╔├„’@Ą─ęųųŲū„ė├ĪŻ
ĪĪĪĪCODĄ─ĮĄĮŌ║═░▒Ą¬▐D╗»▀^│╠Č╝Ģ■ī¦ų┬ŽĄĮyā╚pHĄ─ūā╗»ĪŻ░▒Ą¬č§╗»│╔ü厧╦ß¹}║═Ž§╦ß¹}Ą─▀^│╠ąĶꬎ¹║─ēAČ╚Ż¼įņ│╔ŽĄĮypHŽ┬ĮĄ;┼c┤╦ŽÓĘ┤Ż¼ęę╦ßŌcĮĄĮŌ▀^│╠Ģ■Ž¹║─ę╗Č©Ą─H+Ż¼ī¦ų┬pH╔²Ė▀Ż¼łD4×ķå╬ų▄Ų┌ā╚pHŠC║Žūā╗»Ą─ĮY╣¹ĪŻė╔łD4┐╔ų¬Ż¼▓╗═¼pHŚl╝■Ž┬å╬ų▄Ų┌ŽĄĮypHŠ∙│╩¼FŽ╚╔²Ė▀║¾ĮĄĄ═Ą─┌ģä▌Ż¼▀@┼c«ÉBŠ·┐ņ╦┘ĮĄĮŌCODėąĻPĪŻ«ÉBŠ·ĮĄĮŌėąÖC╬’▀^│╠ųąĢ■┐ņ╦┘Ž¹║─╦«ųąH+Ż¼«a╔·ēAČ╚╩╣pHąĪĘ∙╔Ž╔²Ż¼Č°ļSų°░▒Ą¬č§╗»▀^│╠Ą─▀MąąŻ¼ŽĄĮyā╚H+▒╗Ž¹║─Ż¼ī¦ų┬pHŽ┬ĮĄĪŻ▀M╦«pH▓╗═¼Ż¼å╬ų▄Ų┌▀\ąą▀^│╠ųąFA▓©äė▌^┤¾ĪŻ▀M╦«pH×ķ8.0Ż¼ŽĄĮyā╚FAūŅĖ▀ØŌČ╚┐╔▀_51.88 mg∙L−1Ż¼į┌ų▄Ų┌ĮY╩°ĢrFA×ķ11.40 mg∙L−1;▀M╦«pHĮĄų┴7.5Ż¼ų▄Ų┌ā╚ūŅĖ▀FAØŌČ╚ĮĄĄ═ų┴16.93 mg∙L−1;▀M╦«pHų┴7.0ĢrŻ¼ŽĄĮyā╚FAūŅĖ▀ųĄ×ķ5.53 mg∙L−1ĪŻANTHONISENĄ╚蹊┐░l¼F Ż¼FAī”NOB║═AOB«a╔·ęųųŲū„ė├Ą─ØŌČ╚Ęųäe×ķ0.1~1.0 mgĪżL−1║═10~150 mgĪżL−1Ż¼ĮĄĄ═▀M╦«pHų┴7ū¾ėęŻ¼┐╔ŠÅĮŌĖ▀ØŌČ╚FAī”░▒č§╗»Š·Ą─ęųųŲū„ė├Ż¼╠ß╔²ŽĄĮy░▒Ą¬▐D╗»─▄┴”Ż¼═¼ĢrŽĄĮyųąĄ─FAØŌČ╚ėų┐╔ėąą¦ęųųŲNOBĪŻ╚╗Č°Ż¼FAØŌČ╚▀^Ą═ūĶĄK┴╦░▒č§╗»Š·┼c░▒Ą¬Ą─ĮY║ŽŻ¼ŽĄĮy░▒Ą¬╚ź│²─▄┴”ļyęį└^└m╠ß╔²Ż¼│÷╦«NO2−-N/NH4+-N┌ģė┌ĘĆČ©ĪŻ
ĪĪĪĪłD4 ▓╗═¼│§╩╝pHå╬ų▄Ų┌Ę┤æ¬Ų„ā╚╦«┘|ģóöĄūā╗»
ĪĪĪĪ▀M╦«pHÅ─8.5ĮĄĄ═ų┴7.0Ż¼ŽĄĮyCOD╚ź│²┬╩┬įėą╠ßĖ▀(╚ńłD5╦∙╩Š)Ż¼ŽĄĮyųą│÷¼F┐饬ōp╩¦Ż¼ę▓▒Ē├„COD│²┴╦▒╗ų▒ĮėĮĄĮŌ═ŌŻ¼▀Ćėą╔┘┴┐▒╗ė├ū„Ę┤Ž§╗»╠╝į┤ĪŻŽĄĮy▀\ąąųąĘ┤Ž§╗»Ž¹║─Ą─COD(Ė∙ō■┐饬╚ź│²┴┐ėŗ╦Ń)ļS┐饬╚ź│²┬╩═¼▓Į╔²Ė▀ĪŻ▀M╦«pHė╔8.0ĮĄų┴7.0Ą─▀^│╠ųąŻ¼ŽĄĮy┐éCOD╚ź│²┬╩į÷ķLų„ę¬╩Ūė╔ė┌Ę┤Ž§╗»Ž¹║─╠╝į┤Ż¼COD╚ź│²┬╩į÷╝ė12%ū¾ėęĪŻ▀@ų„ę¬Üwę“ė┌Ņw┴Ż╬’▒Ē├µĄ─«ÉBŠ·║═░▒č§╗»Š·┐ņ╦┘Ž¹║─Ņw┴Ż╬█─Ó▒Ē├µ╚▄ĮŌ觯¼╩╣Ą├Ņw┴Ż╬█─Óā╚▓┐│÷¼F╚▒解hŠ│Ż¼═¼Ģr▌^ČÓĄ─COD┐╔ė├ū„Ę┤Ž§╗»╠╝į┤Ż¼ėąÖC╬’║═ü厧╦ß¹}Įøė╔Ņw┴Ż╬█─Ó▒Ē├µ┐ūŽČ▀M╚ļŲõā╚▓┐Ż¼šT░lŅw┴Ż╬█─Óā╚▓┐«ÉBĘ┤Ž§╗»Š·Ą─į÷ų│ĪŻŠ▀¾w┬ōŽĄ╬█╦«īÜ╗“ģóęŖhttp://www.dongaorq.cnĖ³ČÓŽÓĻP╝╝ąg╬─ÖnĪŻ
ĪĪĪĪłD5 ▀M╦«pHī”COD╚ź│²╝░TN╚ź│²Ą─ė░Ēæ
ĪĪĪĪ2.3 ▀M╦«C/Nī”║├č§Ņw┴Ż╬█─Ó▓┐Ęųü厧╗»Ą─ė░Ēæ
ĪĪĪĪį┌ÅU╦«ųąŻ¼ėąÖC╬’╩Ū╗∙┘|ųąūŅ│ŻęŖĄ─ĮMĘųŻ¼ŪęėąÖC╬’ØŌČ╚ę▓Ģ■╩▄Ė„ĘNę“╦žĄ─ė░ĒæČ°▓©äėŻ¼║▄ļy▀_ĄĮ└ĒŽļĄ─C/N▒╚×ķ2Ż║1Ż¼ėą▒žę¬╠ĮėæC/N▒╚ī”Ņw┴Ż╬█─Óü厧╗»ąį─▄Ą─ė░ĒæĪŻ▒ŠčąŠ┐╠Įėæ┴╦C/N▒╚Ęųäe×ķ2Īó2.4║═2.8ī”Ą¬▐D╗»ąį─▄Ą─ė░ĒæĪŻ
ĪĪĪĪłD6 ▓╗═¼C/N▒╚Śl╝■Ž┬SBRąį─▄ūā╗»
ĪĪĪĪ╚ńłD6╦∙╩ŠŻ¼▀M╦«C/Nė╔2╔²ų┴2.8Ż¼ŽĄĮy░▒Ą¬╚ź│²┬╩ŽÓī”ĘĆČ©Ż¼ü厧╦ß¹}ØŌČ╚Ę┤Č°Ž┬ĮĄŻ¼│÷╦«NO2−-N/NH4+-N│ų└mĮĄĄ═Ż¼ė╔1.0ĮĄĄ═ų┴0.65ū¾ėęŻ¼Ž§╦ß¹}ØŌČ╚ę╗ų▒ŠS│ųį┌▌^Ą═╦«ŲĮĪŻCOD╚ź│²─▄┴”ų▓Į╠ß╔²Ż¼ŽĄĮyCOD╚ź│²žō║╔╠ßĖ▀1.45 kg∙(m3∙d)−1Ż¼ė├ū„═¼▓ĮĘ┤Ž§╗»╠╝į┤CODĄ─╚ź│²žō║╔āH╔²Ė▀0.58 kg∙(m3∙d)−1Ż¼šf├„C/N▒╚į÷╝ėŻ¼ī¦ų┬Ņw┴Ż╬█─Ó▒Ē├µ║├觫ÉBŠ·Ą─┐ņ╦┘į÷ų│Ż¼╩╣Ą├║├č§Ņw┴Ż╬█─ÓCOD╚ź│²ą¦─▄╠ßĖ▀ĪŻŅw┴Ż╬█─Óųą«ÉB╬ó╔·╬’┤¾┴┐į÷ų│Ż¼ūįB╬ó╔·╬’AOBį┌┼cŲõĀÄŖZ╚▄č§▀^│╠ųą╠Äė┌┴ėä▌Ż¼Ģ■Ž„╚§╔§ų┴É║╗»ŽĄĮy░▒Ą¬č§╗»─▄┴”ĪŻŅw┴Ż╬█─ÓĮYśŗĄ─ūā╗»▀Mę╗▓ĮūCīŹ▀@ę╗¼FŽ¾ĪŻ▀M╦«C/N=2.4ĢrŻ¼COD╚▌Ęežō║╔×ķ4.80 kg∙(m3∙d)−1ū¾ėęŻ¼║├č§Ņw┴Ż╬█─Ó┴ŻÅĮ┐ņ╦┘į÷┤¾Ż¼▀@┼cäóąĪ┼¾Ą╚į┌ėąÖCžō║╔×ķ3.20~4.84 kg∙(m3∙d)−1Ģr╦∙Ą├ĮY╣¹ę╗ų┬ĪŻ╚ńłD7╦∙╩ŠŻ¼┤╦ĢrŅw┴Ż╬█─Ó┴ŻÅĮĖ▀▀_7~9 mmŻ¼Ę┤æ¬Ų„ā╚«a╔·┤¾┴┐ą§¾wĪŻ▌^┤¾╬█─Ó┴ŻÅĮ╩╣Ą├Ņw┴ŻĘĆČ©ąį╩▄ĄĮė░ĒæŻ¼╝ėų«Ę┤Ž§╗»«aÜŌī¦ų┬Ņw┴Ż░l╔·ŲŲ╦ķĪŻC/N▒╚į÷╝ėĄĮ2.8ĢrŻ¼┤¾┴┐Ņw┴Ż╬█─Ó░l╔·ŲŲ╦ķŻ¼C/N▒╚Ą─│ų└mį÷Ė▀ī”Ņw┴Ż╬█─ÓĮYśŗįņ│╔┴╦śO┤¾Ą─ŲŲē─ĪŻLUOĄ╚į┌蹊┐C/N▒╚ī”Ņw┴Ż╬█─ÓĮYśŗĘĆČ©ąįųąųĖ│÷Ż¼▀M╦«C/N▒╚į┌1~2ų«ķgŠ▀ėą▌^ĘĆČ©Ą─ĮYśŗŻ¼C/N▒╚Ė▀ė┌2ĢrŅw┴Ż╬█─Óęū░l╔·ŲŲ╦ķĪŻšf├„ęįŽ§╗»×ķ─┐ś╦Ą─║├č§Ņw┴Ż╬█─Ó╠Ä└ĒC/N▒╚Ė▀ė┌2Ą─ÅU╦«Ż¼ęūī¦ų┬Ž§╗»ąį─▄Ž┬ĮĄ╗“Ņw┴ŻĮŌ¾wĪŻ
ĪĪĪĪłD7 ▓╗═¼▀M╦«C/N▒╚Ž┬Ę┤æ¬Ų„ā╚║├č§Ņw┴Ż╬█─Óą╬æBūā╗»
ĪĪĪĪ3 ĮYšō
ĪĪĪĪ1)Ę┼ų├ę╗Č╬ĢrķgĄ─║├č§Ņw┴Ż╬█─Ó═©▀^ų╝ē╠ßĖ▀▀M╦«žō║╔Ż¼─▄┐ņ╦┘åóäėü厧╗»ąį─▄ĪŻ▀M╦«C/N=2Śl╝■Ž┬Ż¼▀M╦«░▒Ą¬ØŌČ╚ė╔100 mg∙L−1╔²ų┴300 mg∙L−1▀^│╠ųąŻ¼ŽĄĮy░▒Ą¬╚ź│²┬╩║═ü厧╦ß¹}└█Ęe┬╩Š∙į┌90%ęį╔ŽŻ¼▀Mę╗▓Į╠ß╔²░▒Ą¬ØŌČ╚ų┴500 mg∙L−1Ż¼ė╔ė┌«ÉBŠ·į÷ų│ī¦ų┬░▒Ą¬č§╗»ąį─▄Ž┬ĮĄĪŻ
ĪĪĪĪ2)▀M╦«pHė╔8.0ĮĄų┴7.0▀^│╠ųąŻ¼▀M╦«FAė╔48.5 mg∙L−1ĮĄĄ═ų┴5.1 mg∙L−1Ż¼ėą└¹ė┌NOB▀xō±ąįęųųŲŻ¼╠ßĖ▀░▒Ą¬╚ź│²┬╩Ż¼│÷╦«NO2−-N/NH4+-N▒╚ųĄÅ─0.5╠ßĖ▀ĄĮ0.95ū¾ėęĪŻCOD╚ź│²┬╩╠ßĖ▀12%Ż¼ų„ę¬╩Ūė╔ė┌═¼▓ĮĘ┤Ž§╗»Ž¹║─╠╝į┤Ą─Šē╣╩ĪŻ
ĪĪĪĪ3)ī”ė┌ąį─▄┴╝║├Ą─ü厧╗»Ņw┴Ż╬█─ÓŻ¼▀M╦«C/N▒╚Å─2╔²ų┴2.8Ż¼«ÉB╬ó╔·╬’┐ņ╦┘į÷ų│Ż¼COD╚ź│²žō║╔╠ßĖ▀1.45 kg∙(m3∙d)−1Ż¼AOB╩▄ĄĮęųųŲŻ¼│÷╦«NO2−-N/NH4+-Nė╔1.0ĮĄĄ═ų┴0.65ū¾ėęŻ¼│÷¼FŅw┴Ż╬█─ÓŲŲ┴čĪóĮŌ¾wĪŻ(üĒį┤Ż║ŁhŠ│╣ż│╠īWł¾ ū„š▀Ż║└Ņäé)